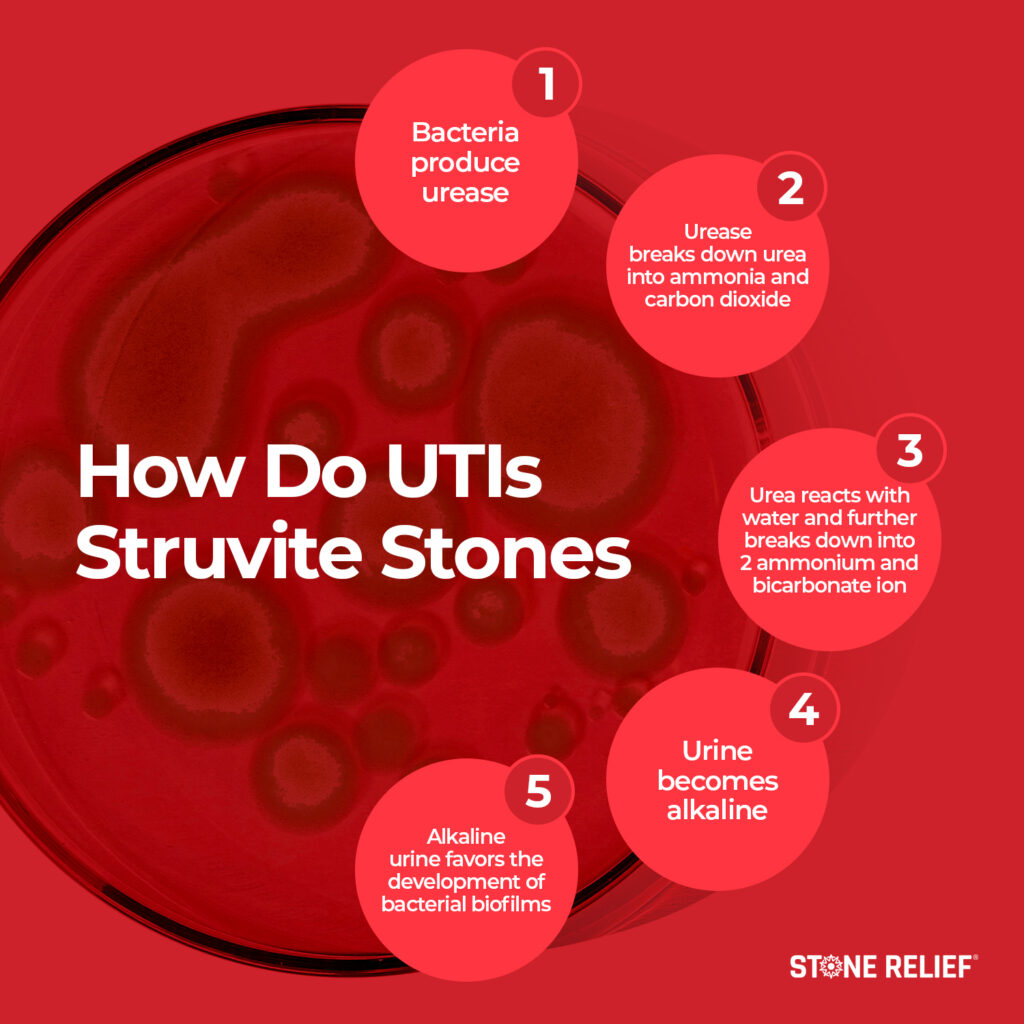

Kidney Stone or UTI? How to Tell the Difference
Kidney stones and UTIs can be hard to tell apart—but they’re often connected in a dangerous cycle. UTIs can lead to kidney stones, and stones can create the perfect environment for UTIs. Learn how to recognize the difference and break the cycle with simple, powerful prevention strategies.
Key Takeaways
-
UTIs can cause kidney stones—especially struvite and calcium phosphate stones
-
Stones can also cause UTIs by creating stagnant urine
-
Alkaline urine, biofilm, and stents increase infection and stone risk
-
Hydration, hygiene, diet, and immunity are your best defenses
If you’ve been bouncing back and forth between urinary tract infections (UTIs) and kidney stones, you're not alone—and you’re not imagining things. These two painful problems are deeply connected.
UTIs can lead to kidney stones.
Kidney stones can lead to UTIs.
And once the cycle starts, it’s hard to stop.
Let’s walk through how this happens and how you can protect yourself with three powerful prevention strategies.
🛒 Check Price & Purchase Stone Relief Pass AM/PM Bundle on Amazon
What Is a UTI, Really?
A urinary tract infection is a bacterial infection that can pop up anywhere in your urinary system. That includes your:
-
Kidneys
-
Ureters
-
Bladder
-
Urethra
UTIs are far more common in women than in men. About 40% of women will experience one at some point, compared to only 12% of men.
But what does this have to do with kidney stones?
More than you might think.
UTIs Can Cause Kidney Stones
UTIs can form a very specific type of stone—struvite and calcium phosphate stones.
Here’s how it happens:
-
The bacteria causing the UTI produce an enzyme called urease
-
Urease breaks down urea (a protein byproduct in your urine)
-
This breakdown creates ammonia and bicarbonate, both of which alkalize your urine
Now you’ve got a problem.
Alkaline urine (pH 8.5–9) creates the perfect environment for calcium phosphate crystals to form.
Even worse? That alkalinity breaks down your urinary tract’s natural defenses.
Once those protective linings are damaged, bacterial biofilms form.
These biofilms act as the foundation for new kidney stones to grow—specifically struvite and calcium phosphate stones.
Kidney Stones Can Also Cause UTIs
The cycle doesn’t stop there.
If you already have a stone, it can obstruct the normal flow of urine, creating stagnant pools in your urinary tract.
And stagnant urine? It’s basically a bacteria buffet.
This creates a feedback loop where stones lead to UTIs, which then increase your risk for more stones.
So how do you stop it?
3 Strategies to Break the UTI-Stone Cycle
1. Practice Smart Hygiene
Bacteria are everywhere—on your skin, in your home, and all over your environment.
That’s not always bad, but when it comes to UTIs, hand and genital hygiene matter.
-
Wash your hands before any interaction with the genitals
-
Skip harsh antibacterial soaps—they kill your natural microbiome
-
Use gentle, surfactant-based soaps to clean the area without stripping away your skin’s defenses
And if you’re a woman, be especially aware.
The shorter distance from the outside to your bladder means more exposure to bacteria.
2. Avoid Unnecessary Ureteral Stents
If you're passing a stone, avoid stents unless they’re absolutely necessary.
Why?
Because stents can:
-
Act as a bacterial breeding ground
-
Interrupt natural stone passage
-
Cause pain and delay healing
Stents are best reserved for:
-
Emergency cases (like hydronephrosis)
-
Severe pain requiring quick urine release
-
Pre-surgical relief, not routine use
We’ve created a helpful resource, the Stent Survival Guide, to walk you through when stents are appropriate. Be sure to check it out.
🛒 Check Price & Purchase Stone Relief Pass AM/PM Bundle on Amazon
3. Build Up Your Immune System
Think of your immune system like home security.
The better the system—deadbolts, alarms, window bars—the harder it is for intruders to get in.
And the same goes for bacteria.
The best way to boost your immunity is by following a species-appropriate, kidney-friendly diet:
-
Animal-based foods like meat, cheese, and dairy
-
Seasonal fruits based on your location
-
No ultra-processed or inflammatory foods
Why does this matter?
Proper nutrition strengthens immunity, and strong immunity keeps bacteria at bay.
When bacteria can’t take hold, you avoid UTIs—and in turn, reduce your risk for kidney stones.
🛒 Check Price & Purchase Stone Relief Pass AM/PM Bundle on Amazon
Final Thoughts: Don’t Get Stuck in the UTI-Stone Loop
If you’ve ever wondered whether you’re dealing with a kidney stone or UTI, the answer might be both. They don’t just look alike—they can feed off each other in a vicious cycle of pain, infection, and stone formation.
But you have the power to stop it.
With better hygiene, smart medical decisions, and a strong immune foundation, you can protect your body from the inside out.

